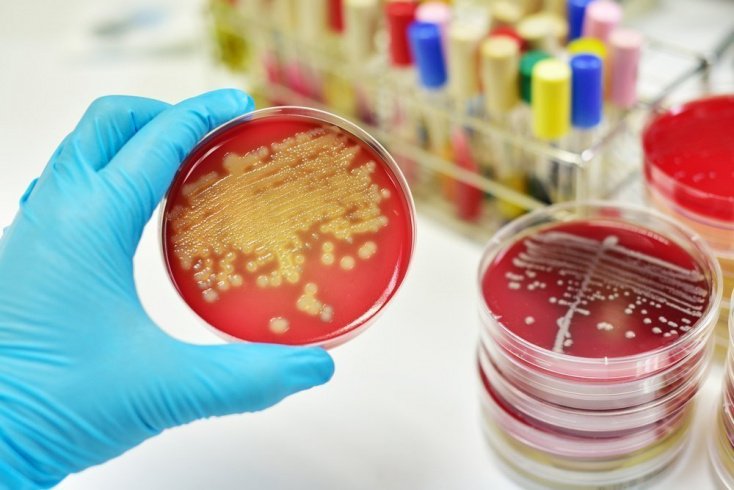

Стрептококковый бактериофаг или антибиотик
Доктор вирус
Эра антибиотиков подходит к концу. Заменят ли их бактериофаги?
Эра антибиотиков подходит к концу. Колоссальный потенциал их воздействия на микробов обесценен человеческим легкомыслием. Теперь многие ученые возлагают надежды на бактериофаги – природные вирусы – разрушители бактерий. Это лекарство буквально лежит у нас под ногами.
Сенсация пришла, откуда не ждали, – с берегов Антарктиды. Пока российские полярники бурили 4-километровый ледяной панцирь над антарктическим озером Восток, стремясь добраться до древних микроорганизмов, шведские исследователи из Университета Упсалы обнаружили бактерии нового типа в морской воде у берегов полярного континента. На первый взгляд это были бактерии самой обычной кишечной палочки, попавшей в океан, судя по всему, вместе с бытовыми отходами соседней чилийской станции Arturo Prat. А необычным в них было то, что эти бактерии способны запросто нейтрализовать активность практически всех известных науке антибиотиков.
Дешево и эксклюзивно
Но еще через 10 лет был открыт пенициллин, который оказался эффективнее в борьбе с микробами. Ведь антибиотики способны уничтожать целые группы разных микроорганизмов, а бактериофаг поражает только один. И чтобы лечить бактериофагом, не обойтись без предварительных точных анализов. Фаги не выдержали конкуренции, их исследование было приостановлено почти повсеместно.
Но не в России. Наши ученые не прекращали исследовать бактериофаги и применять это доступное и недорогое средство в хирургии, при лечении острых кишечных инфекций, дисбактериозов и прочих бед. Приверженцы фаговой терапии утверждают: бактериофагами без каких-либо ограничений и осложнений можно лечить почти все болезни, кроме тех, что вызваны вирусами и простейшими.
Сейчас волна интереса к фагам поднимается и на Западе, хотя там их используют не в лечебных целях, а скорее в профилактических. В США Управление по контролю за качеством пищевых продуктов и лекарственных препаратов (FDA) признало безопасность и целесообразность фагов в качестве БАДов, предотвращающих размножение нежелательных бактерий на сырах, кисломолочных продуктах и мясных полуфабрикатах, – словом, рекомендовало использовать в качестве консервантов. В июне 2011-го отечественный Роспотребнадзор созвал ученый совет, на котором была подписана резолюция о внедрении бактериофагов как нового класса пищевых добавок.
– У бактериофагов могут быть хорошие перспективы, – говорит биолог Андрей Алешкин из лаборатории биологии бифидобактерий Московского НИИ эпидемиологии и микробиологии (МНИИЭМ) им. Г.Н. Габричевского. – Например, их можно использовать и для борьбы со стойкими внутрибольничными инфекциями. Золотистый стафилококк – это большая проблема, в том числе и родильных домов. Можно обкормить рожениц антибиотиками или бесконечно закрываться на мойку, а можно обработать поверхности и инструментарий аэрозольным фагом, даже не нарушая режима учреждения. Роспотребнадзор делает так называемые контрольные смывы на предприятиях пищевой отрасли, в детских учреждениях, больницах, поэтому спектр бактерий, живущих там, известен. И к нему можно подобрать действенный бактериофаг.
Враг моего врага
Сейчас уже известно, что бактериофаг – это вирус, состоящий из ДНК и белковой оболочки. Как и все вирусы, он размножается только в живых клетках хозяина. При этом, в отличие от антибиотиков, бактериофаги не нарушают нормальную микрофлору организма. Они способны присоединяться только к единственному типу микробов, а остальным не причиняют вреда. Проникнув внутрь болезнетворной клетки, ДНК фага начинает воспроизводство себе подобных. Размножившись, бактериофаги разрывают оболочку клетки-хозяина и атакуют другие микробы.
Первым делом в 20-х годах прошлого века стафилококковым фагом начали лечить кожные заболевания. А Феликс Д'Эрелль на посту инспектора службы здравоохранения Лиги Наций использовал фаговую терапию в борьбе со вспышками инфекционных заболеваний на Среднем Востоке и в Индии.
В то же время грузинский последователь Д'Эрелля Георгий Элиава при поддержке наркома советской тяжелой промышленности Серго Орджоникидзе основал в Тбилиси Институт исследования бактериофагов. Институт имел большую научную и производственную базу со своими клиниками, он стал всемирным центром фаговой терапии инфекционных заболеваний. В 1937-м по приказу Берии Георгий Элиава был расстрелян как враг народа, но его институт продолжал работать вплоть до распада СССР.
Изначально бактериофаги выпускали в жидком виде. Затем были разработаны таблетки с кислотоустойчивым покрытием, удобные для употребления и транспортировки, а также концентрат, линимент и гель. При этом сейчас в России используют как препараты с одним действующим вирусом, так и комбинированные (от 2 до 8 видов бактериофагов).
– Чаще всего мы используем бактериофаги при кишечной инфекции, – рассказывает педиатр-инфекционист Татьяна Москалева, которая назначает эти препараты больным детям практически ежедневно. – Они хорошо работают, когда известен возбудитель болезни и проверена его чувствительность к фагам. Тогда лекарство действует направленно, сохраняется нормальная флора, а побочные эффекты практически отсутствуют. Претензии у меня разве что к органолептическим свойствам – уж больно они невкусные. Вот сальмонеллезный бактериофаг в таблетках – приемлемый. А жидкие формы имеют очень неприятный вкус и запах, и это создает сложности при лечении маленьких детей.
Врачи признают, что при вспышках таких инфекций, как пневмония, они скорее будут назначать пациентам интенсивные антибиотики. Но в ряде случаев антибиотики бессильны, а помогают именно фаги. Например, в период подъема заболеваемости дифтерией в 1990-х годах в России многие не болели сами, но являлись носителями инфекции – лежали в больнице месяцами без какого-либо лечебного эффекта. Антибиотики не срабатывали, и на помощь пришли бактериофаги. Та же ситуация сейчас с сальмонеллезом: те люди, которые сами не болеют, но переносят бактерии, чаще излечиваются не антибиотиками, а фагами.
Вместо или вместе
Когда в лаборатории консультативно-диагностического центра при МНИИЭМ им. Г.Н. Габричевского пациенту делают анализ микрофлоры и находят какой-нибудь микроб, то обязательно проводят пробы на чувствительность этого микроба и к спектру антибиотиков, и к спектру бактериофагов. Бактериофагом стоит лечиться только при высокой чувствительности к нему бактерий, но даже в этом случае врачи не могут гарантировать лечебного эффекта.
– В организме не так все просто, как в чашке Петри из лаборатории, – говорит Татьяна Москалева. – Микроб может быть покрыт пленкой, и бактериофаг не сумеет к нему присоединиться. Или может иметь место симбиоз нескольких микробов, тогда реакция тоже будет другой.
За долгую историю фаговой терапии российские исследовательские центры собрали богатую базу (ею сейчас очень интересуются западные микробиологи). Крупнейший музей микроорганизмов, в том числе и фагов, хранится в Научном центре экспертизы средств медицинского применения Минздравсоцразвития России. Здесь поддерживаются в жизнеспособном состоянии тысячи штаммов болезнетворных бактерий, к ним же были выведены вирусы, которые до сих пор используются для производства препаратов бактериофагов.
– В этом может быть проблема, – говорит Андрей Алешкин. – Фаги могут разрушать только тот микроб, против которого они выведены. Фаги, которые производят в России с 1995 года, адресованы тем штаммам бактерий, которые хранятся в музее. А как насчет современных микробов?
В принципе же селекция бактериофагов значительно проще и дешевле, чем производство новых антибиотиков. Каждый тип бактерий имеет свои фаги, и они могут быть выделены в любом месте существования этих бактерий: из сточных вод, фекалий или почвы.
Есть, впрочем, и доводы против фаговой терапии, один звучит так: фаги, встраиваясь в геном бактериальной клетки, могут переносить генетический материал от одной бактерии к другой, а это ведет к развитию защитного механизма у микробов.
– Лабораторные опыты показывают, что такое возможно, но на практике в нашей стране это не подтверждалось, – объясняет Андрей Алешкин. – Иначе после применения бактериофага появилась бы суперинфекция с нетипичной для данного вида возбудителя симптоматикой. Чтобы исключить это, нужно использовать фаги только после определения их чувствительности к выделенной от пациента микрофлоре. Нужно очищать препараты от умеренных фагов, которые, встроившись в бактерию, не разрушают ее, а какое-то время сосуществуют с ней. Необходимо продолжать исследования и обмениваться данными с производителями.
Ученые ведут работы над генно-инженерными препаратами – планируется использовать только ДНК фага без оболочки, чтобы максимально увеличить эффективность. Создают комбинированные препараты – бактериофаги сочетают с бактериоцинами (ферментами бактерий), с интерфероном. А еще фаги применяют в тандеме с антибиотиками, чтобы многократно увеличить шансы победы над болезнью.
– Ставить крест на антибиотиках все-таки еще рано, – разъясняет профессор Михаил Фаворов. – Они будут становиться все более дорогими и менее доступными, но решающую роль в борьбе с бактериями пока что играть продолжат, возможно, при участии вспомогательных средств, вроде бактериофагов. А для разработки научно обоснованной стратегии использования фагов в медицине было бы важно проведение всеобъемлющего стандартизированного клинического испытания фагосодержащих медицинских препаратов. Пока результаты таких испытаний не опубликованы ни у нас, ни за рубежом.
При повышенной активности стрептококка врачи назначают медицинский препарат стрептококковый бактериофаг, который можно купить без рецепта в свободной продаже. Реальные отзывы пациентов и подробное изучение инструкции не должны становиться руководством к применению, требуется дополнительная консультация специалиста.
Что такое стрептококковый бактериофаг
Если своевременно не истребить патогенную флору, болезнь усиливает свою симптоматику, чревата серьезными осложнениями для здоровья. Стрептококковый бактериофаг - это специфический медикамент, который относится к фармакологической группе иммунобиологических препаратов. Активный компонент – живые бактериофаги, которые при взаимодействии с вредными стрептококками продуктивно истребляют последних. Бактериальный лизат содержится в специальном растворе, который имеет индивидуальную дозировку, предназначен для применения внутрь перорально и подкожно.
Бактериофаг стрептококковый активен в отношении всех видов Streptococcus, а присутствующий в натуральном составе лизат укрепляет ослабленный иммунитет, дополнительно тренирует иммунные клетки. Такое консервативное лечение актуально только по назначению лечащего врача, который дополнительно определяет подходящую форму выпуска, дозу, курс интенсивной терапии, согласно преобладающему заболеванию.
Инструкция по применению
Самолечение полностью исключено в любом возрасте. Подробная инструкция по применению стрептококкового бактериофага сообщает о показаниях и противопоказаниях, оговаривает потенциальные побочные явления, случаи передозировки. Основные плюсы назначения бактериофага стрептококкового – натуральный состав, мягкое действие в организме, устойчивый лечебный эффект, неограниченная возрастная категория пациентов. Минусом такого лечения становится избирательное действие на очаг патологии. В этом случае врачам предстоит подобрать более эффективный аналог.

Бактериофаг обладает выраженным антистрептококковым эффектом, используется для взрослых и в схеме интенсивной терапии у новорожденных. Прежде чем лечить стрептококковую инфекцию, требуется определить этиологию патологического процесса и определить эффективное лечение. Основные медицинские показания к применению стрептококкового бактериофага, отраженные в подробной инструкции, таковы:
- Гнойно-воспалительные процессы ЛОР-практики и дыхательных путей: синусит, воспаление среднего уха (отит), стрептококковый ринит, тонзиллит, воспаления пазух носа, ларингит, фарингит.
- Урогенитальные инфекции: хронический пиелонефрит, воспаление придатков матки у женщин, хирургические инфекции после проведения операции, уретрит, кольпит, цистит, сальпингоофорит, эндометрит, прогрессирующий простатит у мужчин.
- Инфекция нижних дыхательных путей: бронхит, трахеит, плеврит, пневмония, воспаление легких. Уместно такое назначение при ангине и других заболеваниях горла, склонных к нагноению, формированию абсцессов.
- Воспалительные процессы кожных покровов инфекционного характера: пиодермия, карбункулы, нагноения ран, ожоги, флегмона, гидраденит, фурункулы, абсцессы, любые инфекции стрептококкового происхождения.
- Инфицирование органов ЖКТ: дисбактериоз кишечника, гастроэнтероколит, энтеральные инфекции, эмпиема желчного пузыря, панкреатит, холецистит, парапроктит, любые расстройства пищеварительной системы.
- Гнойно-воспалительные болезни у новорожденных: энтероколит, сепсис, пиодермия, омфалит, конъюнктивит.
- Стрептококковый абсцесс: любые поражения мягких тканей с последующим инфицированием и нагноением.
- Генерализованные септические заболевания.
- Реабилитационный период после хирургического лечения, профилактика бактериофагом стрептококковым: мастит, парапроктит, абсцесс, бурсит, панариции, остеомиелит.
Это жидкое лекарство от стрептококков пользуется в современной медицине ощутимым спросом, его одинаково назначают взрослым и детям. Однако такое консервативное лечение и профилактика разрешены не всем пациентам. В инструкции отражены медицинские противопоказания стрептококкового бактериофага, которые ограничивают список возможностей характерного медикамента. Это:
- повышенная активность организма к натуральным компонентам бактериофага;
- хроническая склонность к аллергическим реакциям;
- повышенная активность других бактерий, штаммов, нечувствительных к живым бактериофагам.

Лечебный раствор предназначен для применения внутрь и наружно, а зависит способ использования лекарства и его суточные дозировки от характера патологического процесса, возраста клинического больного. Все назначения делает только лечащий врач. Рекомендованная в подробной инструкции дозировка стрептококкового бактериофага представлена ниже, может корректироваться сугубо индивидуально. Это:
- Орошение кожи и слизистых оболочек при воспалительном процессе инфекционного происхождения.
- Катетеризация при обострении инфекций половых органов и мочевого пузыря, внутримышечные инфекции – при воспалении подкожной клетчатки.
- Полоскание ротовой полости для продуктивного лечения заболеваний горла, стоматологических инфекций. Дополнительно разрешено использование аэрозоля раствора.
- Пероральный прием бактериофага стрептококкового с целью лечения патологий органов ЖКТ: суточная доза для взрослых – 25-40 мл, для детей – 5-15 мл.
- Тампонирование – введение в полость наружного уха, носовые проходы в зависимости от преобладающего очага патологии.
- Вдыхание аэрозоля раствора для этиологической терапии воспаления верхних и нижних дыхательных путей.
- Ректальное введение бактериофага стрептококкового для лечения нижних отделов органов ЖКТ при суточных дозах лекарства 10-50 мл.
- Примочки и промывание дермы в случае поражения мягких тканей с последующим инфицированием и нагноением.
- Введение в суставные или плевральные полости до 100 мл, после оставляют капиллярный дренаж для поступления на протяжении нескольких дней бактериофага стафилококкового.
- Лекарство можно колоть в объеме 2-10 мл до трех раз в сутки при гнойно-воспалительных заболеваниях ЛОР-практики.
Прежде чем начать лечение бактериофагом стрептококковым, требуется исследовать сыворотку крови на предмет обнаружения болезнетворной инфекции. Только по рекомендации врача можно заказать и купить в интернет-магазине это лекарство, использовать его строго по медицинским показаниям. Побочные эффекты стрептококкового бактериофага на практике отсутствуют, однако в единичных случаях на коже могут возникнуть местные, аллергические реакции.

Аналоги бактериофага стрептококкового
Если указанного препарата нет в продаже, либо его действие на практике оказалось слабым, посредственным, необходимо совместно с лечащим врачом ввести не менее достойную замену. Самые распространенные аналоги стрептококкового бактериофага тоже можно встретить в каталогах интернет-аптек, их стоимость разная, но обязательно одобрение специалиста. Как вариант, это могут быть следующие медикаменты:
- Пиобактериофаг;
- Бактериофаг клебсиелл пневмонии;
- Бактериофаг поливалентный;
- Стрептофаг;
- Бактериофаг протейный, стафилококковый и колипротейный.
Цена на стрептококковый бактериофаг
Для кого-то указанный медикамент стоит недорого, а кто-то считает его стоимость в аптеке излишне завышенной, недоступной. Цена в интернет-аптеке ниже розничных аптечных расценок, поэтому виртуальная покупка выгодней для пациента. Прежде чем купить лекарство, лучше посоветоваться с врачом, определить аптеку с самой низкой ценой на бактериофаг стрептококковый. Ниже представлены места, где можно купить указанный медицинский препарат.
Название аптеки в Москве
Аптека оптовых цен
Видео
Отзывы
Марина, 31 год Давала бактериофаг старшему ребенку при дисбактериозе кишечника внутрь. Препарат абсолютно безвредный, не вызывает отвращения и побочных эффектов. После прохождения полного курса у дочки нормализовался стул, исчезло неприятное вздутие, пришло в норму общее самочувствие. Очень довольна таким назначением участкового педиатра.
Светлана, 40 лет Давняя ссадина на руке превратилась в гнойную рану. Первое время я ее посыпала Банеоцином, но не очень помогло. Врач порекомендовал сначала делать примочки бактериофагом стрептококковым, а потом сыпать порошковый антибиотик. Положительный результат от такого комплекса был уже на вторые сутки после выполнения процедуры, рука пошла на поправку.
Илона, 25 лет Мне бактериофаг назначили при кольпите, но результатом такого лечения я не довольна, только 800 рублей зря потратила. Неприятные симптомы не исчезли, а болезнетворная инфекция только усилила свое действие в организме. Пришлось срочно менять лекарство, хотя врач меня убеждала в его высокой эффективности при моей пикантной проблеме.
Анна, 33 года При гнойной ангине полоскала больное горло только этим лечебным раствором по 3 раза в сутки. Гнойные пробки вскоре исчезли, прошел острый приступ боли, стало легче глотать и даже начала нормально кушать. Лечение быстрое и эффективное, хотя сам препарат стоит недешево. Рекомендую всем, поскольку побочных эффектов от него все равно не бывает.

Ч ем лечить бактериальную инфекцию у детей? По этому вопросу у врачей есть разные мнения, поэтому его широко обсуждают и мамы, которым часто предстоит делать непростой выбор. Поговорим про антибиотики и бактериофаги, их плюсы и минусы.
Спасибо сэру Александру Флемингу за поистине величайшее открытие: первый из известных антибиотиков – пенициллин – был открыт им в 1920-е годы. Массовое производство было налажено во время Второй мировой войны, и это спало огромное количество жизней. По сей день антибиотиками лечатся миллионы людей, хотя за последние сто лет появилось множество других методов для борьбы с бакинфекциями.


Большое количество противопоказаний (детский возраст, беременность, кормление грудью и др.).
Частые аллергические реакции.
И самая главная проблема – резистентность, то есть устойчивость организма к их воздействию.
Семнадцать лет назад, когда я только начала учиться в медицинском колледже, самым любимым и действующим препаратом у медиков был один известный антибиотик – его назначали направо и налево, так как он был действительно эффективным и имел мало побочных реакций. Сейчас на своём опыте работы врачом-педиатром я вижу, что этот препарат действует не каждый раз. А всё потому, что бактерии адаптировались к этому препарату и мутировали, поэтому лечение часто является неэффективным. И так не только с этим антибиотиком, но и со многими другими.
Поэтому всё чаще для лечения бактериальной инфекции назначают бактериофаги. Кстати, открыли бактериофаги на десять лет раньше пенициллина, но в связи с широким применением антибиотиков про бактериофаги надолго забыли.
Бактериофаги – это вирусы, которые поражают бактериальные клетки. Чем же хороши бактериофаги в лечении бактериальной инфекции?

Основные плюсы бактериофагов:
Очень низкая вероятность развития резистентности и аллергических реакций.
Узконаправленность, то есть определённый бактериофаг действует на определённую бактерию, при этом остальная микрофлора организма человека остается неизменной.
И самый большой плюс – отсутствие противопоказаний из-за того, что фаги не влияют на процессы, проходящие в организме.
Но всё же с большим количеством преимуществ бактериофаги не являются заменой антибиотикам, а лишь альтернативным вариантом лечения.

Видов бактериофагов много – стрептококковый, клебсиеллёзный, пиобактериофаг, протейный, колипротейный и др. – в нашей стране применяется в общей сложности 13 препаратов на основе фагов. Самый известный – дизентерийный бактериофаг: благодаря ему предотвратили дизентерийную эпидемию после больших наводнений в крупных городах России.
Многие гастроэнтерологи говорят о том, что лечение бакинфекции нужно начинать именно с фагов – тогда риск возникновения осложнений меньше. Бывает так, что анализ выявляет, что к фагам у бактерии резистентность, в то время как чувствительность есть только к антибиотикам определённой группы. Поэтому если ситуация не критическая, то лечение нужно начинать с бактериофагов, а антибиотики оставить как запасной вариант. Вот такие это волшебные вирусы, которые не губят, а восстанавливают здоровье людей.
Поиск эффективных средств в борьбе с бактериальными инфекциями продолжается уже не первое столетие. И конечно, открытие первого антибиотика пенициллина еще в 1920-х годах стало прорывом в данном направлении. Активное использование этого лекарства во время Второй мировой войны принесло ему всемирную известность. С тех пор антибиотики – основа лечения многих заболеваний. Почему же все чаще в медицинском сообществе возникают вопросы о развитии альтернативных видов препаратов, разбирался MedAboutMe.
Когда необходим прием антибиотиков

Антибиотики – препараты, активные против различных видов бактерий. Некоторые из них могут уничтожать лишь несколько видов микроорганизмов, другие же обладают широким спектром действия. Именно препараты второго типа используются при лечении большинства бактериальных заболеваний, поскольку могут применяться еще до анализа крови, который и покажет тип возбудителя инфекции. Это важно в случае необходимости экстренного лечения.
Прием антибиотиков целесообразен только при наличии болезни, вызванной бактериями:
- Воспаление легких (стафилококки и стрептококки).
- Ангина (чаще вызвана стрептококками).
- Гнойные воспаления, в том числе заражение крови – сепсис.
- Ботулизм.
- Краснуха.
- Корь.
- Коклюш.
- Пневмококковая инфекция.
- Сальмонеллез.
- Гонорея.
При таких инфекциях, как грипп, ОРВИ, гепатиты и прочее, антибиотики не помогают, поскольку болезни вызваны вирусами.
Проблемы антибактериального лечения: эффективность лекарств

Антибиотики приобрели большую популярность и очень активно использовались в медицинской практике. Однако вскоре выявились некоторые существенные проблемы, связанные с этими препаратами.
Многие такие лекарства нельзя выписывать детям, беременным, людям с хроническими заболеваниями почек и печени. А именно эти категории находятся в группе риска по осложнениям. Сегодня выпускаются антибактериальные медикаменты, которые разрешено применять перечисленным категориям пациентов, однако это все равно ограниченный круг препаратов.
Прием антибиотиков часто заканчивается дисбактериозом. Связано это с тем, что многие препараты первого ряда (в том числе пенициллины, цефалоспорины, макролиды) обладают широким спектром действия. А это значит, что они уничтожают не только болезнетворные, но и полезные бактерии.
Наиболее важная проблема в контексте будущего антибактериальной терапии. Бесконтрольный прием антибиотиков, использование их без назначения и для профилактики привело к тому, что многие бактерии стали устойчивыми к препаратам. Например, сегодня обнаруживается немало штаммов золотистого стафилококка, которые способны разрушать пенициллины – медикаменты, которые изначально использовались именно против стафилококковых инфекций. Все чаще фиксируются случаи неэффективности рифампицина – антибиотика против туберкулеза. Ученые постоянно синтезируют новые поколения медикаментов, однако резистентность бактерий все равно остается существенной проблемой.
Аналоги лекарств антибиотиков – бактериофаги

На смену антибиотикам вполне могут прийти альтернативные лекарства – бактериофаги. Стоит сказать, что именно в этом направлении развивалась медицина в начале ХХ века, но с открытием антибиотиков о фагах на долгие годы забыли.
Это живые и активные вирусы, которые поражают бактерии. Как известно, любой вирус может размножаться только в живой клетке, и фаги используют для этого разные виды микробов.
Сегодня у такого лечения есть очевидные плюсы, которые делают его перспективным направлением. Среди них:
- Низкая вероятность развития резистентности.
Бактериофаги – не изобретенное средство, эти микроорганизмы сегодня считаются наиболее древней группой вирусов. Они широко распространены во внешней среде, где активно уничтожают различных бактерий. И при этом современные исследования показывают их эффективность, например, по отношению к 90% выделенных штаммов стафилококка.
- Не влияют на другие бактерии.
Если антибиотики уничтожают флору без разбора, бактериофаги, как и другие вирусы, узкоспециализированы. Они способны поражать только определенный тип микробов, а полезная микрофлора находится при этом в безопасности.
Как уже говорилось, бактериофаги активны только по отношению к конкретной бактерии, они не взаимодействуют с другими веществами, не влияют на процессы, проходящие в организме. Поэтому могут назначаться всем, в том числе детям, беременным и людям с заболеваниями почек.
- Низкая вероятность аллергической реакции.
Антибиотики – одни из наиболее распространенных препаратов, которые могут вызывать лекарственную аллергию. Причем нередки случаи тяжелых ее форм, в том числе и смертельно опасной анафилаксии. На вирусы такой реакции иммунной системы не наблюдается.
И все же сегодня бактериофаги – пока лишь условные аналоги лекарств антибиотиков. Прописываются они реже, поскольку все еще есть ряд связанных с ними проблем:
- Узкая специализация лекарства.
Эта характерная черта фагов помогает предотвращать дисбактериоз, однако в некоторых случаях становится существенным минусом для лечения. Дело в том, что некоторые бактериальные инфекции, особенно у детей, развиваются стремительно, и помощь нужна экстренная. В таких случаях врачи сразу, еще до получения результатов анализов, прописывают антибиотик широкого спектра действия. На тот момент, когда на руках оказываются лабораторные исследования с подтвержденным возбудителем, лечение уже идет. С бактериофагами такие экстренные меры пока невозможны.
Современные антибиотики пропиваются за 5-7 дней, есть и такие, которые принимаются 3 дня. А вот курс лечения бактериофагами может продолжаться до 1 месяца и разбивается на несколько этапов.
Золотистый стафилококк и его лечение
Золотистый стафилококк – одна из наиболее активных болезнетворных бактерий человека, которая способна вызывать множество различных заболеваний: от гнойного поражения кожи до сепсиса. Именно этот вид микроба активно мутирует и легко приобретает резистентность к антибиотикам. Очень быстро бактерия выработала устойчивость к первым пенициллинам, научившись синтезировать фермент пенициллиназу, способный разрушать лекарство. Сейчас в отдельную группу выделяют метициллинрезистентный золотистый стафилококк – микроб, с множественной лекарственной устойчивостью. Болезни, вызванные им, развиваются быстро, прием антибиотиков разных групп не дает результата, очень высок процент смертности среди пациентов.
Наиболее часто устойчивые стафилококки встречаются в стенах больниц, существует даже специфическое определение – больничная инфекция. Новые поколения антибиотиков быстро становятся неэффективными, но при этом существует альтернатива – стафилококковый бактериофаг, к которому чувствительны разные виды Staphylococcus aureus. Сегодня он все чаще назначается пациентам с подтвержденной стафилококковой инфекцией. В некоторых случаях он может использоваться в комплексном лечении, но эффективен при монотерапии и даже в качестве профилактики.
Читайте также:


